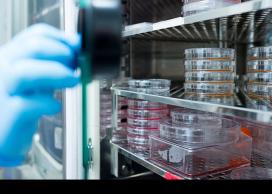
RFSG

Updates, news and stories
A selection of updates, news and stories from across the university.
-
 UBCV & UBCOSeptember 24, 2024 | Feature story | Faculty & Staff
UBCV & UBCOSeptember 24, 2024 | Feature story | Faculty & StaffFrom oral tradition to comics: Homalco First Nation partner with UBC and Education Without Borders to create graphic novel based on the stories of their Elders
-
UBCVSeptember 23, 2024 | UBC Bulletin | Faculty & Staff
Call for Proposals for Open Educational Resource Grants
Faculty and staff in Vancouver are invited to submit proposals for grants that support the use of open educational resources (OER) in UBC Vancouver credit courses. OER are freely accessible educational materials that permit open use, modification, and adaptation.OER Affordability Grants
-
 UBCV & UBCOSeptember 23, 2024 | Announcement | Faculty & Staff
UBCV & UBCOSeptember 23, 2024 | Announcement | Faculty & StaffAnnouncing the recipients of the 2024 President's Awards for staff
Congratulations to the recipients of the 2024 President's Service Awards for Excellence and the President's Staff Awards.These awards are presented annually by the university to recognize staff members who demonstrate outstanding achievement and excellence within the UBC community.Find out more
-
 UBCOSeptember 23, 2024 | Announcement | Faculty & Staff
UBCOSeptember 23, 2024 | Announcement | Faculty & StaffNominations open for Okanagan teaching awards
Nominations are now open for 2024/25 UBC Okanagan teaching awards.Provost’s Award for Teaching Excellence and Innovation:This award acknowledges and celebrates teaching excellence and innovation at UBC’s Okanagan campus. The successful award recipient(s) will be exemplary role models who have and will continue to have a significant impact on the culture of teaching and learning on the Okanagan campus, and beyond.Killam Teaching Prize:
-
 UBCVSeptember 23 | Feature story | Staff
UBCVSeptember 23 | Feature story | StaffBuilding a culture where learning and community can thrive
-
 UBCVSeptember 20, 2024 | Media release | Faculty & Staff
UBCVSeptember 20, 2024 | Media release | Faculty & StaffGender-diverse youth feeling more welcome at home, less welcome in public
-
UBCVSeptember 19, 2024 | Announcement | Faculty
UBCVSeptember 19, 2024 | Announcement | FacultyApply for Research Facility Support Grants by Nov. 1
The Research Facility Support Grants (RFSG) competition provides funding for the operation, maintenance, replacement, repair or upgrade of equipment used in UBC facilities to support research. The RFSGs are one-year grants of up to $50,000 intended to enhance UBC research, training, and equipment sustainability. Researchers located on the UBC Vancouver campus and affiliated hospital sites are eligible to apply by Nov. 1.
-
 UBCVSeptember 19, 2024 | Feature story | Faculty & Staff
UBCVSeptember 19, 2024 | Feature story | Faculty & StaffStories of Partnership: A Conversation with AMSSA & UBC’s Centre for Migration Studies
-
 UBCOSeptember 18, 2024 | Media release | Faculty & Staff
UBCOSeptember 18, 2024 | Media release | Faculty & StaffUBCO researcher explores how the home environment affects a child’s learning
-
 UBCOSeptember 18, 2024 | Announcement | Faculty & Staff
UBCOSeptember 18, 2024 | Announcement | Faculty & StaffNine interdisciplinary teams selected to move into x̌əl sic snpax̌nwixʷtn
Nine interdisciplinary research teams are set to move into x̌əl sic snpax̌nwixʷtn, UBC Okanagan’s newest building, in March 2026.Solutions to some of society’s most important issues will be investigated by the teams, including: immunotherapies, climate adaptation, and communication and language connected to social and mental health. The teams were selected after a review process that saw applicants showcase the potential impact of their research, the importance of an interdisciplinary approach and how the new, innovative space would be used.
-
 UBCV & UBCOSeptember 17, 2024 | Media release | Faculty & Staff
UBCV & UBCOSeptember 17, 2024 | Media release | Faculty & StaffOpportunities and challenges for BC housing ahead of the election
-
UBCVSeptember 16, 2024 | UBC Bulletin | Faculty & Staff
Call for proposals for Small Teaching and Learning Enhancement Fund Innovation projects
Proposal submissions for Small Teaching and Learning Enhancement Fund (TLEF) Innovation projects are open to faculty, students, and staff at UBC Vancouver. The deadline for proposals is 3pm on November 14.About Small TLEF Innovation projects
